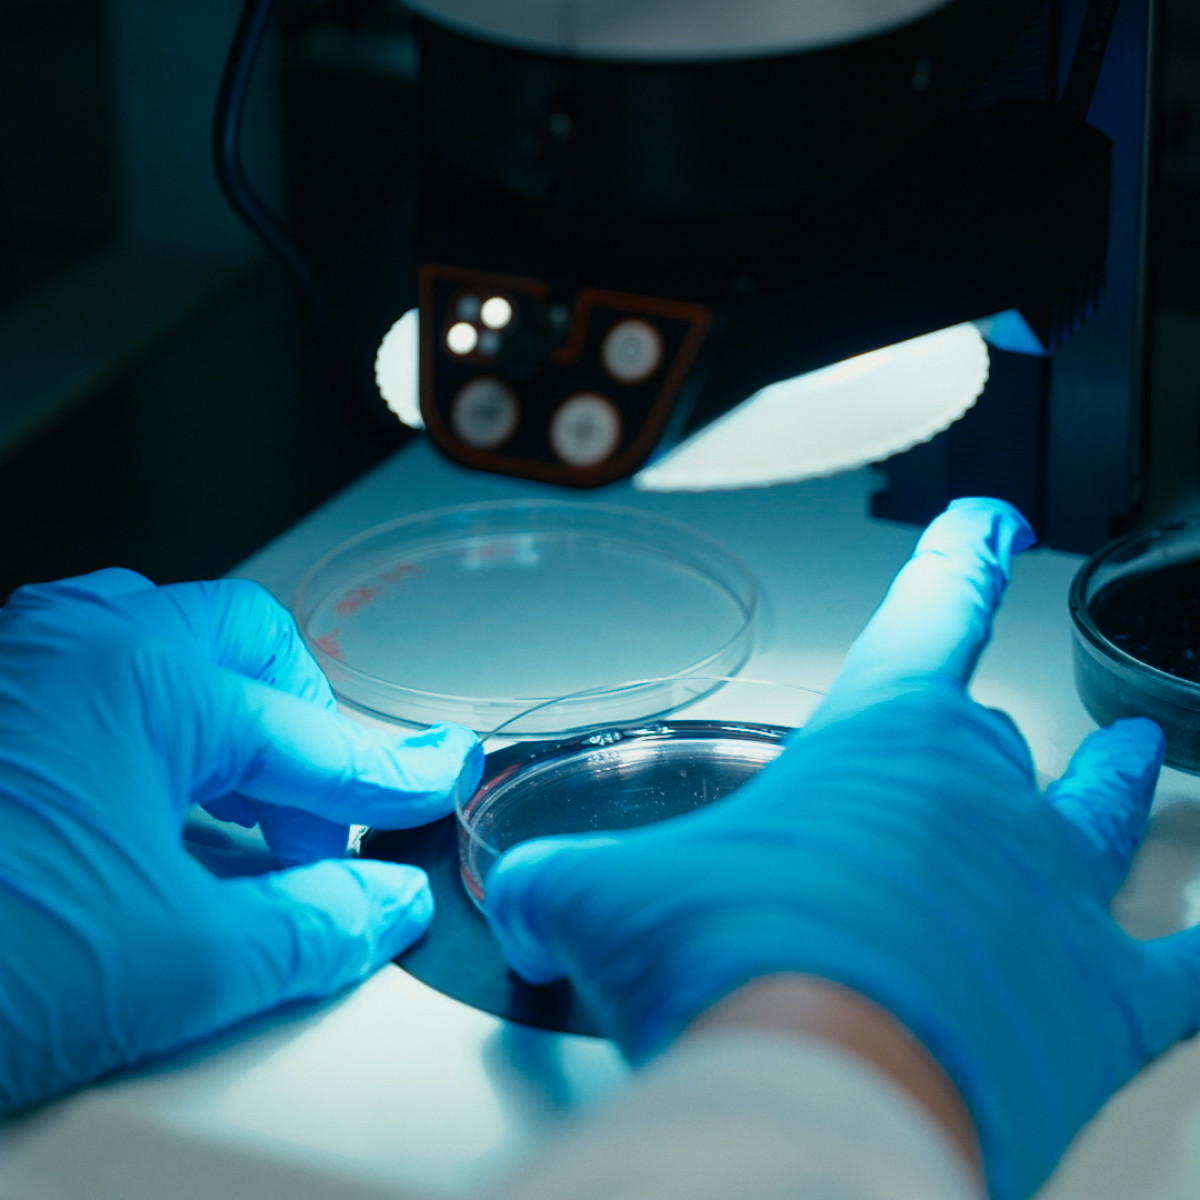

Organisatiestructuur DON

Stichting Diabetes Onderzoek Nederland (DON) is een kleine organisatie met één doel: diabetes type 1 genezen. Vanuit ons kantoor in Amsterdam werkt een toegewijd team dagelijks aan het realiseren van deze missie. We doen dit samen met een betrokken bestuur, een deskundige raad van toezicht, een wetenschappelijke raad, zeer betrokken ambassadeurs en de DONNIES.
DON kent vier organen: een toezichthoudend, besturend, uitvoerend en adviserend orgaan. De raad van toezicht houdt toezicht op het bestuur, denkt mee over koers en strategie, en ziet erop toe dat de stichting op een verantwoorde manier wordt aangestuurd. Het bestuur draagt verantwoordelijkheid voor het strategisch beleid en speelt daarnaast een actieve rol in fondsenwerving. De onderzoeksvoorstellen worden beoordeeld door de wetenschappelijke raad, die tevens advies uitbrengt aan het bestuur.
Daarnaast helpt deze raad bij het beoordelen van de voortgang van de onderzoeken die DON financieel steunt. De dagelijkse leiding ligt bij de directeur, die – samen met het team – verantwoordelijk is voor het opstellen en uitvoeren van het meerjarenbeleid, het jaarplan en de begroting. Het team op kantoor houdt zich bezig met het organiseren van alle projecten, evenementen en fondsenwervende activiteiten, met als constante leidraad: maximale impact voor genezing.
Alle leden van de raad van toezicht, de wetenschappelijke raad en het bestuur werken op vrijwillige basis, zijn onbezoldigd en brengen aanzienlijke expertise en ervaring in. In de statuten van DON staan de taken van de organen vastgelegd. De raad van toezicht en het bestuur komen gemiddeld twee keer per jaar samen. Het bestuur vergadert vijf keer per jaar.
Als ANBI-stichting hechten we veel waarde aan transparantie, doelmatigheid en zorgvuldigheid in de omgang met de middelen die we ontvangen. Dat vraagt om heldere processen, onafhankelijk toezicht en de bereidheid om voortdurend te verbeteren.

Erevoorzitter Maarten de Gruyter Maarten
Maarten is de oprichter van DON, die op achtjarige leeftijd zelf de diagnose diabetes type 1 kreeg. In de loop van zijn leven merkte hij dat de focus bij diabetes type 1 vooral lag op care, het verbeteren van de kwaliteit van leven van patiënten. Vanuit de wens om meer aandacht te vragen voor cure, ofwel genezing, richtte hij in 2006 Stichting Diabetes Onderzoek Nederland (DON) op. Inmiddels heeft de stichting al vele onderzoeken gefinancierd en komt de genezing van diabetes type 1 steeds een stapje dichterbij.

Bestuur
Peter Frans Pauwels: voorzitter
Lucas Brentjens: penningmeester
Robert de Jonge: secretaris
Uneke Dekkers
Jaap Boender
Karin van Leeuwen
Jeroen Tas

Raad van toezicht
Mr. P.W. (Pieter) Akkerman
H.A.A. (Arnold) de Haan
Mr. B.P. (Bert) Bolkenstein
M.I. (Isabel) Fernandez Niemann
Wetenschappelijke raad
Dr. K.P. (Paul) Bouter
Prof. dr. H.J.G. (Henk) Bilo
Prof. dr. E.J.P. (Eelco) de Koning
Prof. dr. R.O.B. (Rijk) Gans
Drs. N.C. (Nienke) Miltenburg
Drs. M.E. (Mark) Seubert